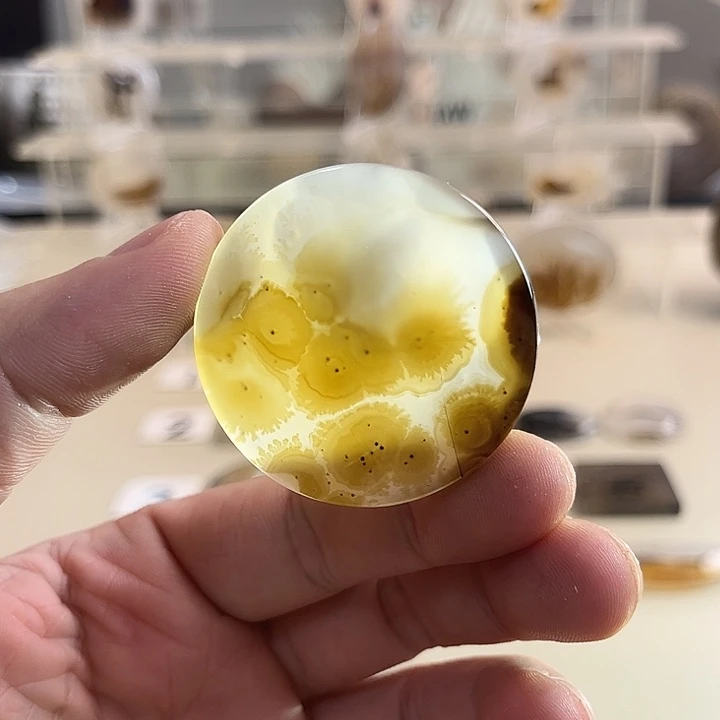

玛瑙/玉髓吊坠(不含链)未镶嵌
分类
关联品牌UNKNOWN
总评论数
优惠券无
快递免运费
数据概览
销量 25w~50w
关联达人数 3
关联直播数 15
关联视频数 44
销售方式分布
来源
占比
销量
视频
0.0%
0
直播
0.0%
0
商品卡
0.0%
0
数据趋势
相似商品
分类
关联品牌UNKNOWN
总评论数
优惠券无
快递免运费
销量 25w~50w
关联达人数 3
关联直播数 15
关联视频数 44
来源
占比
销量
视频
0.0%
0
直播
0.0%
0
商品卡
0.0%
0